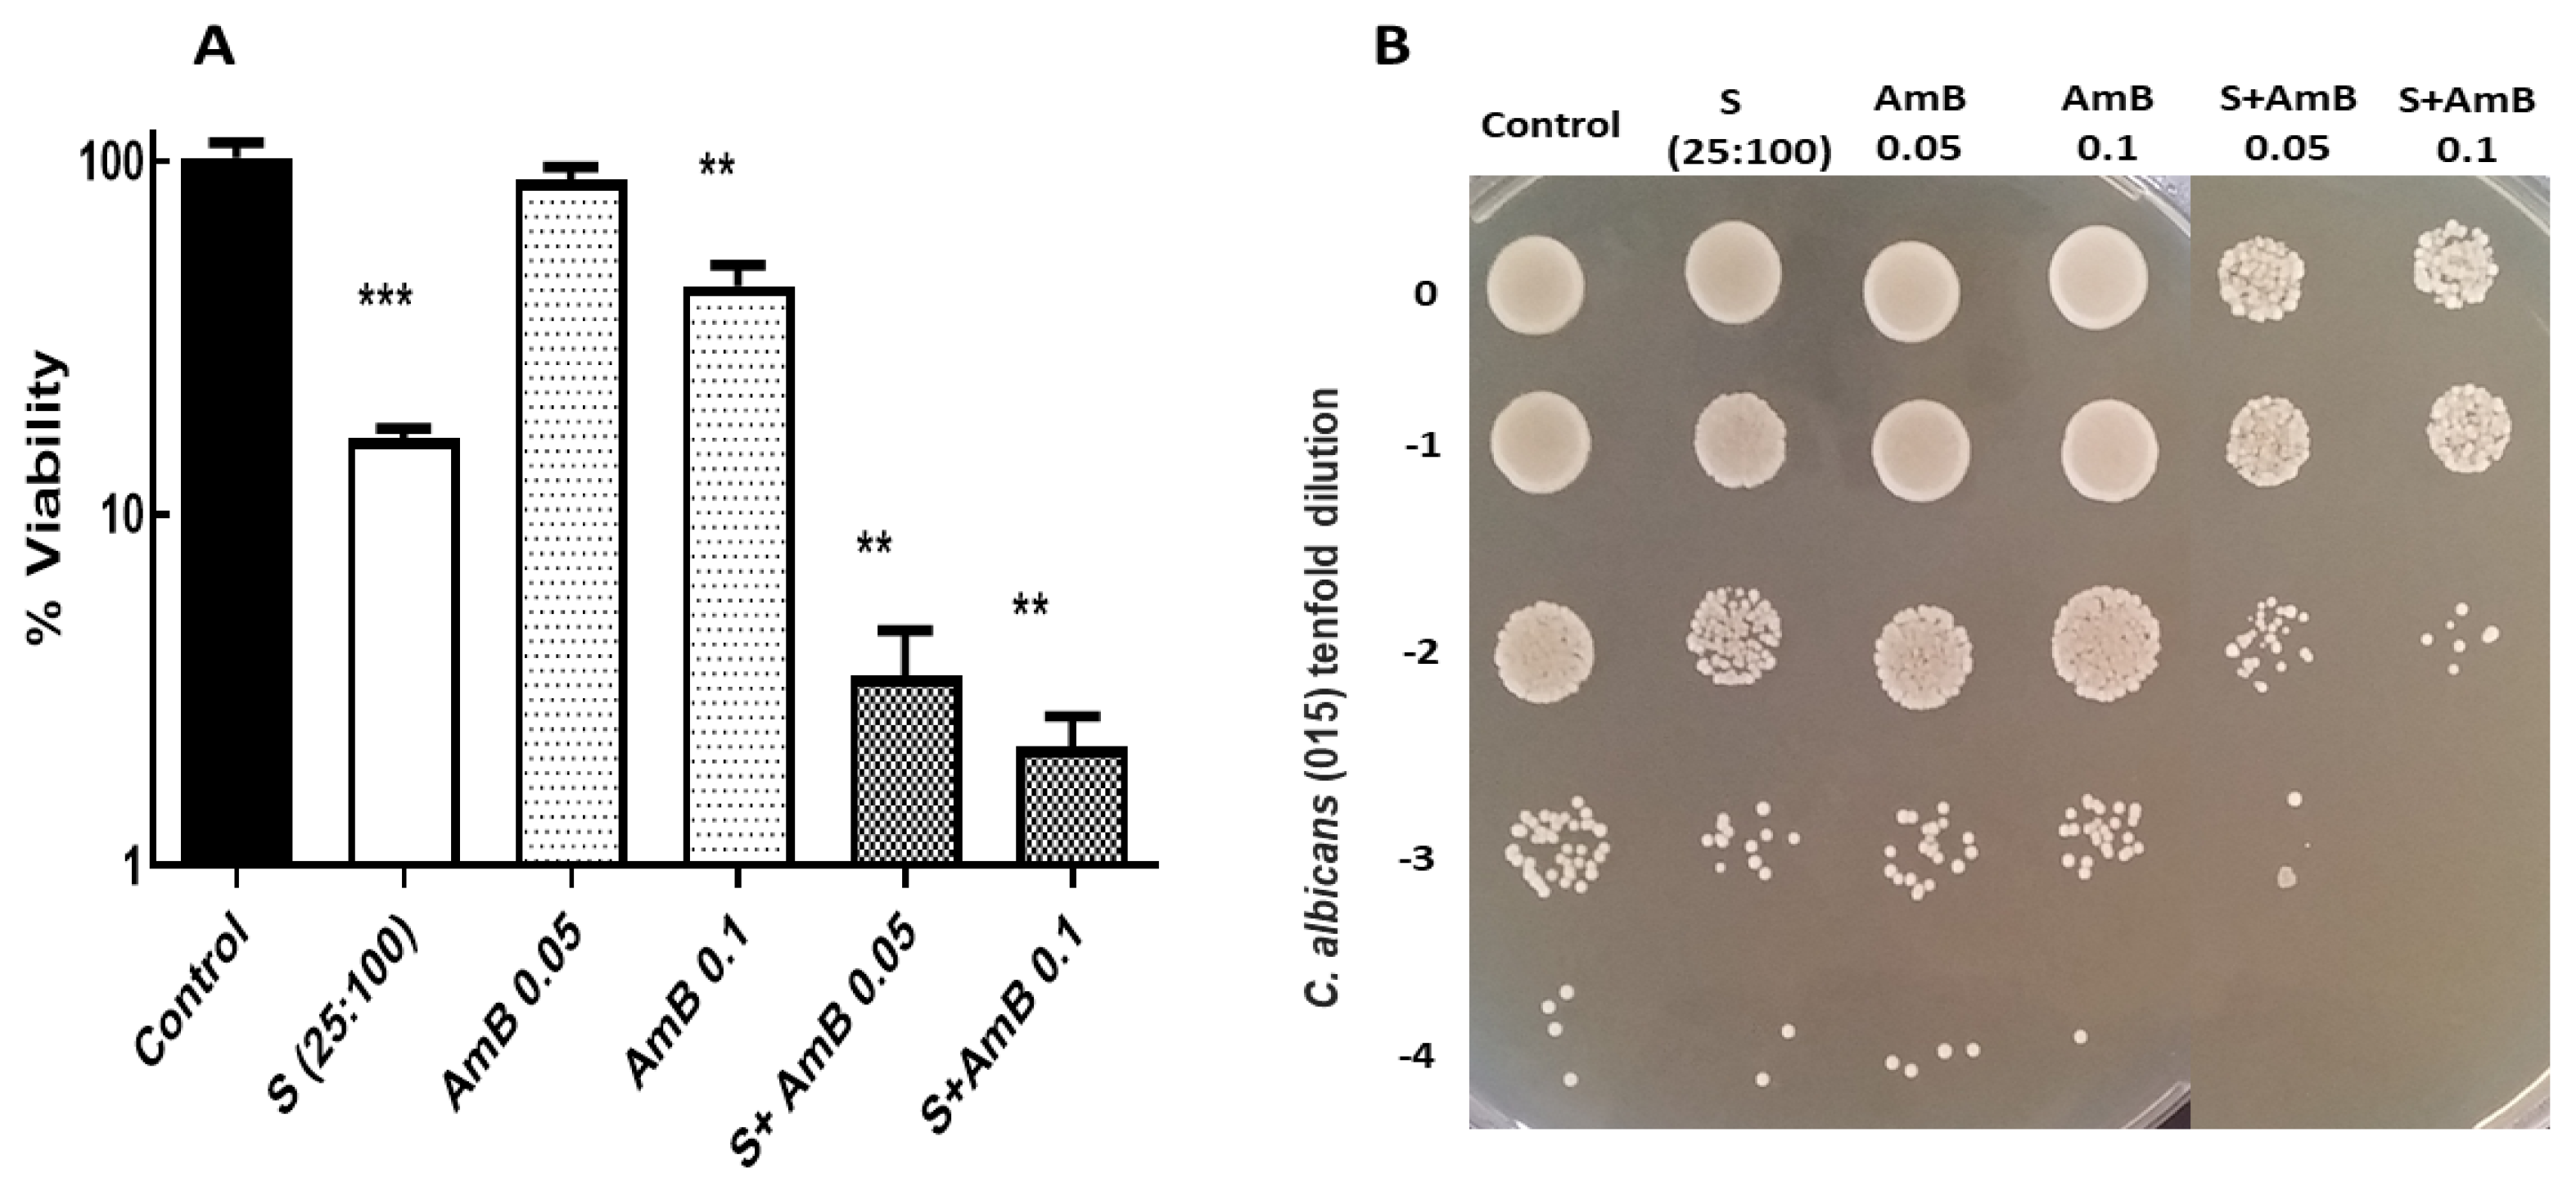
Jof 09 00442 g003

Insight into the Antifungal Effects of Propolis and Carnosic Acid—Extension to the Pathogenic Yeast Candida glabrata: New Propolis Fractionation and Potential Synergistic Applications
Abstract
:1. Introduction
2. Materials and Methods
2.1. Yeast Strains and Culture Conditions
2.2. Determination of Cell Viability
2.3. Natural Sources and Ethanolic Fractionation of PP in Solid Columns
2.4. HPLC
3. Results and Discussion
3.1. The Synergistic Fungicidal Effect of CA and PP Can Be Extended to Other Emerging Yeasts
3.2. Potential Fungicidal Activity Achieved by Combination of CA-PP Mixtures and A Conventional Antifungal, Amphotericin B
3.3. Hydroalcoholic Fractionation of Raw Propolis
4. Conclusions and Perspectives
Supplementary Materials
Author Contributions
Funding
Institutional Review Board Statement
Informed Consent Statement
Data Availability Statement
Acknowledgments
Conflicts of Interest
References
- Brown, G.D.; Denning, D.W.; Gow, N.A.R.; Levitz, S.M.; Netea, M.G.; White, T.C. Hidden killers: Human fungal infections. Sci. Transl. Med. 2012, 4, 165rv13. [Google Scholar] [CrossRef] [PubMed] [Green Version]
- Denning, D.W.; Bromeley, M.J. Infectious disease: How to bolster the antifungal pipeline. Science 2015, 347, 1414–1416. [Google Scholar] [CrossRef] [PubMed] [Green Version]
- Patterson, T.F. Advances and challenges in management of invasive mycoses. Lancet 2005, 366, 1013–1025. [Google Scholar] [CrossRef]
- Almeida, F.; Rodrigues, M.L.; Coelho, C. The still underestimated problem of fungal diseases worldwide. Front. Microbiol. 2019, 10, 214. [Google Scholar] [CrossRef] [PubMed] [Green Version]
- Al Aboody, M.S.; Mickymaray, S. Anti-fungal efficacy and mechanisms of flavonoids. Antibiot 2020, 9, 45. [Google Scholar] [CrossRef] [PubMed] [Green Version]
- Rodrigues, M.L.; Nosanchuk, J.D. Fungal diseases as neglected pathogens: A wake-up call to public health officials. In Advances in Clinical Immunology, Medical Microbiology, COVID-19, and Big Data; Jenny Stanford Publishing: Dubai, United Arab Emirates, 2021; pp. 399–411. [Google Scholar]
- Kainz, K.; Bauer, M.A.; Madeo, F.; Carmona-Gutierrez, D. Fungal infections in humans: The silent crisis. Microb. Cell 2020, 7, 143. [Google Scholar] [CrossRef]
- Pfaller, M.A.; Castanheira, M. Nosocomial candidiasis: Antifungal stewardship and the importance of rapid diagnosis. Med. Mycol. 2016, 54, 1–22. [Google Scholar] [CrossRef] [Green Version]
- Pfaller, M.A.; Diekema, D.J. Epidemiology of invasive mycoses in North America. Crit. Rev. Microbiol. 2010, 36, 1–53. [Google Scholar] [CrossRef]
- Shor, E.; Perlin, D.S. Coping with stress and the emergence of multidrug resistance in fungi. PLoS Pathog. 2015, 11, e1004668. [Google Scholar] [CrossRef] [Green Version]
- Gintjee, T.J.; Donnelley, M.A.; Thompson, G.R. Aspiring antifungals: Review of current antifungal pipeline developments. J. Fungi 2020, 6, 28. [Google Scholar] [CrossRef] [Green Version]
- Ivanov, M.; Ciric, A.; Stojkovic, D. Emerging antifungal. Targets and strategies. Int. J. Mol. Sci. 2022, 23, 2756. [Google Scholar] [CrossRef]
- Campoy, S.; Adrio, J.L. Antifungals. Biochem. Pharmacol. 2017, 133, 86–96. [Google Scholar] [CrossRef] [PubMed]
- Belenky, P.; Camacho, D.; Collins, J.J. Fungicidal drugs induce a common oxidative-damage cellular death pathway. Cell Rep. 2013, 3, 350–358. [Google Scholar] [CrossRef] [PubMed] [Green Version]
- Cereghetti, D.M.; Carreira, E.M. Amphotericin B: 50 years of chemistry and biochemistry. Synthesis 2006, 6, 914–942. [Google Scholar] [CrossRef]
- Saliba, F.; Dupont, B. Renal impairment and amphotericin B formulations in patients with invasive fungal infections. Med. Mycol. 2008, 46, 97–112. [Google Scholar] [CrossRef] [Green Version]
- Sokol-Anderson, M.L.; Brajtburg, J.; Medoff, G. Amphotericin B-induced oxidative damage and killing of Candida albicans. J. Infect. Dis. 1986, 154, 76–83. [Google Scholar] [CrossRef]
- Guirao-Abad, J.P.; Sánchez-Fresneda, R.; Alburquerque, B.; Hernández, J.A.; Argüelles, J.C. ROS formation is a differential contributory factor to the fungicidal action of Amphotericin B and Micafungin in Candida albicans. Int. J. Med. Microbiol. 2017, 307, 241–248. [Google Scholar] [CrossRef]
- Guirao-Abad, J.P.; Sánchez-Fresneda, R.; Román, E.; Plá, J.; Argüelles, J.C.; Alonso-Monge, R. The MAPK Hog1 mediates the response to Amphotericin B in Candida albicans. Fungal Genet. Biol. 2020, 136, 103302. [Google Scholar] [CrossRef]
- McCarthy, M.W.; Kontoyiannis, D.P.; Cornely, O.A.; Perfect, J.R.; Walsh, T.J. Novel Agents and Drug Targets to Meet the Challenges of Resistant Fungi. J. Infect. Dis. 2017, 216, S474–S483. [Google Scholar] [CrossRef] [Green Version]
- Argüelles, A.; Sánchez-Fresneda, R.; Guirao-Abad, J.P.; Belda, C.; Lozano, J.A.; Solano, F.; Argüelles, J.C. Novel bi-factorial strategy against Candida albicans viability using Carnosic acid and Propolis: Synergistic antifungal action. Microorganisms 2020, 8, 749. [Google Scholar] [CrossRef] [PubMed]
- Argüelles, A.; Sánchez-Fresneda, R.; Martínez-Mármol, E.; Lozano, J.A.; Solano, F.; Argüelles, J.C. A specific mixture of Propolis and Carnosic acid triggers a strong fungicidal action against Cryptococcus neoformans. Antibiotics 2021, 10, 1395. [Google Scholar] [CrossRef] [PubMed]
- Birtić, S.; Dussort, P.; Pierre, F.X.; Bily, A.C.; Roller, M. Carnosic acid. Phytochemistry 2015, 115, 9–19. [Google Scholar] [CrossRef] [PubMed] [Green Version]
- Bankova, V. Chemical diversity of propolis and the problem of standardization. J. Ethnopharm. 2005, 100, 114–117. [Google Scholar] [CrossRef] [PubMed]
- Huang, S.; Zhang, C.P.; Wang, K.; Li, G.Q.; Hu, F.L. Recent advances in the chemical composition of Propolis. Molecules 2014, 19, 19610–19632. [Google Scholar] [CrossRef] [Green Version]
- Romo-Vaquero, M.; Selma, M.V.; Larrosa, M.; Obiol, M.; García-Villalba, R.; González-Barrio, R.; Issaly, N.; Flanagan, J.; Roller, M.; Tomás-Barberán, F.A.; et al. A rosemary extract rich in carnosic acid selectively modulates caecum microbiota and inhibits β-glucosidase activity, altering fiber and short chain fatty acids fecal excretion in lean and obese female rats. PLoS ONE 2014, 9, e94687. [Google Scholar] [CrossRef]
- Cigut, T.; Polak, T.Z.; Gasperlin, L.; Raspor, P.; Jamnik, P. Antioxidative activity of Propolis extract in yeast cells. J. Agric. Food Chem. 2011, 59, 11449–11455. [Google Scholar] [CrossRef]
- Orsolic, N. Allergic inflammation: Effect of propolis and its flavanoids. Molecules 2022, 27, 6694. [Google Scholar] [CrossRef]
- Pfaller, M.A.; Andes, D.R.; Diekema, D.J.; Horn, D.L.; Reboli, A.C.; Rotstein, C.; Azie, N.E. Epidemiology and outcomes of invasive candidiasis due to non-albicans species of Candida in 2496 patients: Data from the prospective antifungal therapy (PATH) registry 2004–2008. PLoS ONE 2014, 97, e101510. [Google Scholar]
- Van Ende, M.; Timmermans, B.; Vanreppelen, G.; Siscar-Lewis, S.; Fischer, D.; Wijnants, S.; Van Dijck, P. The involvement of the Candida glabrata trehalase enzymes in stress resistance and gut colonization. Virulence 2021, 12, 329–345. [Google Scholar] [CrossRef]
- Frías-de-León, M.G.; Hernández-Castro, R.; Conde-Cuevas, E.; García-Coronel, I.H.; Vázquez-Aceituno, V.A.; Soriano-Ursúa, M.A.; Martínez-Herrera, E. Candida glabrata antifungal resistance and virulence factors, a perfect pathogenic combination. Pharmaceutics 2021, 13, 1529. [Google Scholar] [CrossRef]
- Martínez-Herrera, E.; Frías-De-León, M.G.; Hernández-Castro, R.; García-Salazar, E.; Arenas, R.; Ocharan-Hernández, E.; Rodríguez-Cerdeira, C. Antifungal resistance in clinical isolates of Candida glabrata in Ibero-America. J. Fungi 2021, 8, 14. [Google Scholar] [CrossRef] [PubMed]
- De Oliveira, A.E.; da Conceição, E.C.; Leles, M.I. Multiresponse optimization of an extraction procedure of carnosol and rosmarinic and carnosic acids from rosemary. Food Chem. 2016, 211, 465–473. [Google Scholar] [CrossRef] [PubMed]
- Benavente-García, O.; Castillo, J.; Lorente, J.; Ortuño, A.; del Rio, J.A. Antioxidant activity of phenolics extracted from Olea Europaea L. leaves. Food Chem. 2000, 68, 457–462. [Google Scholar] [CrossRef]
- Rossi, S.A.; de Oliveira, H.C.; Agreda-Mellon, D.; Lucio, J.; Mendes-Giannini, M.J.S.; García-Cambero, J.P.; Zaragoza, O. Identification of off-patent Drugs that show synergism with Amphotericin B or that present antifungal action against Cryptococcus neoformans and Candida Spp. Antimicrob. Agents Chemother. 2020, 64, 1–16. [Google Scholar] [CrossRef]
- Ożarowski, M.; Karpiński, T.M.; Alam, R.; Łochyńska, M. Antifungal Properties of Chemically Defined Propolis from Various Geographical Regions. Microorganisms 2022, 10, 364. [Google Scholar] [CrossRef]
- Agüero, M.B.; Svetaz, L.; Sánchez, M.; Luna, L.; Lima, B.; López, M.L.; Tapia, A. Argentinean andean Propolis associated with the medicinal plant Larrea Nitida Cav. (Zygophyllaceae). HPLC–MS and GC–MS characterization and antifungal activity. Food Chem. Toxicol. 2011, 49, 1970–1978. [Google Scholar] [CrossRef]
- Thammasit, P.; Iadnut, A.; Mamoon, K.; Khacha-ananda, S.; Chupradit, K.; Tayapiwatana, C.; Kasinrerk, W.; Tragoolpua, Y.; Tragoolpua, K. A Potential of Propolis on major virulence factors of Cryptococcus neoformans. Microb. Pathog. 2018, 123, 296–303. [Google Scholar] [CrossRef]
- Mamoon, K.; Thammasit, P.; Iadnut, A.; Kitidee, K.; Anukool, U.; Tragoolpua, Y.; Tragoolpua, K. Unveiling the properties of Thai stingless bee propolis via diminishing cell wall-associated Cryptococcal melanin and enhancing the fungicidal activity of macrophages. Antibiotics 2020, 9, 420. [Google Scholar] [CrossRef]
- Gucwa, K.; Kusznierewicz, B.; Milewski, S.; van Dijck, P.; Szweda, P. Antifungal activity and synergism with azoles of Polish Propolis. Pathogens 2018, 7, 56. [Google Scholar] [CrossRef] [Green Version]
- Khan, S.; Khan, S.; Misba, L.; Sharief, M.; Hashmi, A.; Khan, A.U. Synergistic fungicidal activity with low doses of eugenol and amphotericin B against C. Albicans. Biochem. Biophys. Res. Commun. 2019, 518, 459–464. [Google Scholar] [CrossRef]
- Stepanović, S.; Antić, N.; Dakić, I.; Švabić-Vlahović, M. In vitro antimicrobial activity of propolis and synergism between propolis and antimicrobial drugs. Microbiol. Res. 2003, 158, 353–357. [Google Scholar] [CrossRef] [PubMed]
- Pedreño, Y.; Gimeno-Alcaniz, J.V.; Matallana, E.; Argüelles, J.C. Response to oxidative stress caused by H2O2 in Saccharomyces cerevisiae mutants deficient in trehalase genes. Arch. Microbiol. 2002, 177, 494–499. [Google Scholar] [PubMed]
- Alvarez-Peral, F.J.; Zaragoza, O.; Pedreño, Y.; Argüelles, J.C. Protective role of trehalose during severe oxidative stress caused by hydrogen peroxide and the adaptive oxidative stress response in Candida albicans. Microbiology 2002, 148, 2599–2606. [Google Scholar] [CrossRef] [PubMed] [Green Version]
- Baginski, M.; Resat, H.; Borowski, E. Comparative molecular dynamics simulations of amphotericin B–cholesterol/ergosterol membrane channels. Biochim. Biophys. Acta 2002, 1567, 63–78. [Google Scholar] [CrossRef] [PubMed] [Green Version]
- Scudellari, M. The science myths that will not die. Nature 2015, 528, 322–325. [Google Scholar] [CrossRef] [Green Version]

| Fraction | Concentration (µg/mL) | Recovered mg (%) |
|---|---|---|
| Raw PP applied | 500 | 100 |
| H2O | 12.55 | 2.51 |
| EtOH25% | 5.62 | 1.13 |
| EtOH50% | 21.38 | 4.28 |
| TEtOH75% | 124.33 | 24.87 |
| EtOH100% | 122.08 | 24.42 |
Disclaimer/Publisher’s Note: The statements, opinions and data contained in all publications are solely those of the individual author(s) and contributor(s) and not of MDPI and/or the editor(s). MDPI and/or the editor(s) disclaim responsibility for any injury to people or property resulting from any ideas, methods, instructions or products referred to in the content. |
© 2023 by the authors. Licensee MDPI, Basel, Switzerland. This article is an open access article distributed under the terms and conditions of the Creative Commons Attribution (CC BY) license (https://creativecommons.org/licenses/by/4.0/).
Share and Cite
Argüelles, A.; Sánchez-Fresneda, R.; Guirao-Abad, J.P.; Lozano, J.A.; Solano, F.; Argüelles, J.-C. Insight into the Antifungal Effects of Propolis and Carnosic Acid—Extension to the Pathogenic Yeast Candida glabrata: New Propolis Fractionation and Potential Synergistic Applications. J. Fungi 2023, 9, 442. https://doi.org/10.3390/jof9040442
Argüelles A, Sánchez-Fresneda R, Guirao-Abad JP, Lozano JA, Solano F, Argüelles J-C. Insight into the Antifungal Effects of Propolis and Carnosic Acid—Extension to the Pathogenic Yeast Candida glabrata: New Propolis Fractionation and Potential Synergistic Applications. Journal of Fungi. 2023; 9(4):442. https://doi.org/10.3390/jof9040442
Chicago/Turabian StyleArgüelles, Alejandra, Ruth Sánchez-Fresneda, José P. Guirao-Abad, José Antonio Lozano, Francisco Solano, and Juan-Carlos Argüelles. 2023. "Insight into the Antifungal Effects of Propolis and Carnosic Acid—Extension to the Pathogenic Yeast Candida glabrata: New Propolis Fractionation and Potential Synergistic Applications" Journal of Fungi 9, no. 4: 442. https://doi.org/10.3390/jof9040442
APA StyleArgüelles, A., Sánchez-Fresneda, R., Guirao-Abad, J. P., Lozano, J. A., Solano, F., & Argüelles, J.-C. (2023). Insight into the Antifungal Effects of Propolis and Carnosic Acid—Extension to the Pathogenic Yeast Candida glabrata: New Propolis Fractionation and Potential Synergistic Applications. Journal of Fungi, 9(4), 442. https://doi.org/10.3390/jof9040442







